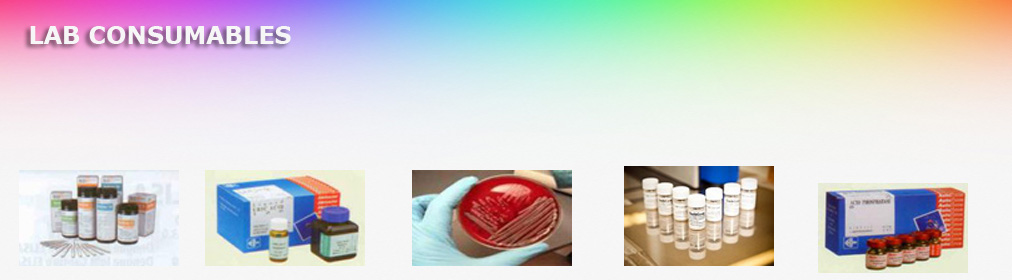

Welcome to our website
Anjan Distributors was incorporated in the year 1992 & it is the first invitro diagnostics company in Bangalore to import Bio- Medical automation & consumables
We are super stockiest for
- Alere Abbott Medical Pvt Ltd
- Siemens Healthcare Pvt Ltd (Blood gas products, Urine analyzer products, Coagulation)
- Accurex Biomedicals Pvt. Ltd.
- Meril Diagnostics Pvt Ltd
We are stockiest for Karnataka for
- Biomerieux India Pvt Ltd
- Tosoh India Pvt Ltd
- Nihon Khoden
- Ark diagnostics
- Transasia Biomedicals Ltd (ERBA)
- Agappe Diagnostics
- Biolab
- Radiometer
- J mitra
- Arkay Healthcare Pvt Ltd
We are providing service, support and reagents to the existing cell counter, Bio chemistry analyzer, Blood Gas Analyzer, Electrolyte Analyzer, Urine Analyzer and Point of care Products.
Anjan Distributors is an organization of young & dynamic people having state of the art technology products and has been one stop solution for Biochemistry, Hematology, Immunology, Coagulation, Blood gas, Electrolytes, Urine chemistry, Rapid tests, Lab Equipment's and Lab Consumables.
Anjan Expertise has rich Experience of handling invitro diagnostics products & services.